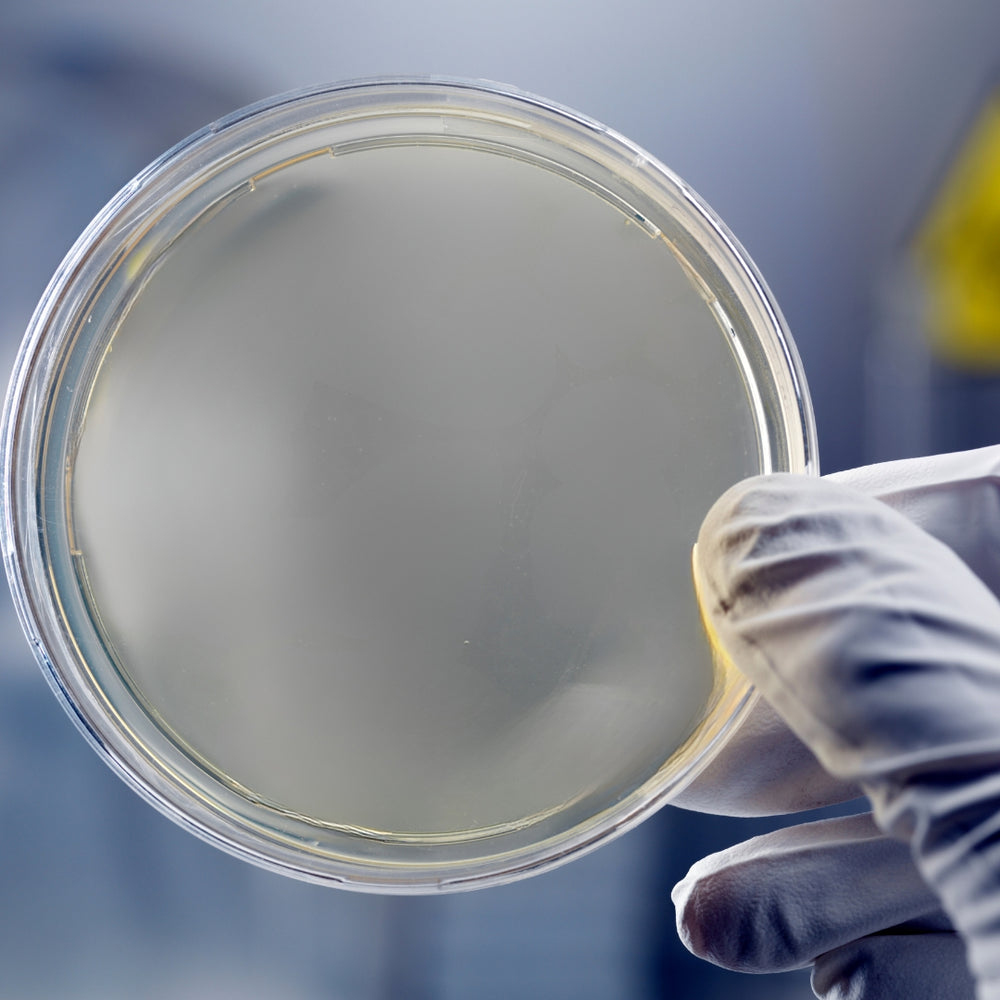

מבצע Black Friday
מבצע Black Friday
מבצע Black Friday
מבצע Black Friday
מבצע Black Friday
מבצע Black Friday
מבצע Black Friday
מבצע Black Friday
מבצע Black Friday
מבצע Black Friday
מבצע Black Friday
מבצע Black Friday
מבצע Black Friday
מבצע Black Friday
מבצע Black Friday
מבצע Black Friday
מבצע Black Friday
מבצע Black Friday
מבצע Black Friday
מבצע Black Friday
מבצע Black Friday
מבצע Black Friday
מבצע Black Friday
מבצע Black Friday
מבצע Black Friday
מבצע Black Friday
מבצע Black Friday
מבצע Black Friday
מבצע Black Friday
מבצע Black Friday
מבצע Black Friday
מבצע Black Friday
מבצע Black Friday
מבצע Black Friday
מבצע Black Friday
מבצע Black Friday
האם מברשת השיניים שלכם באמת נקייה?
האם ידעתם שמברשות השיניים שלנו עלולות להכיל מעל 10 מיליון חיידקים?
צחצוח שיניים הוא דבר בסיסי שכולנו עושים באופן יומיומי, וחלקנו אפילו מצחצחים מספר פעמים ביום.
מברשת השיניים שלכם אולי נראית תמימה, אבל היא למעשה מגנט לחיידקים.
מברשת השיניים שלכם חשופה לזיהומים ליד הכיור (מנתזי מים ולכלוך) ובחדר השירותים (חיידקים שמתפזרים מהאסלה בעת הדחת מים עם מכסה פתוח).
פתרון קל, פשוט ויעיל!
הצוות המתקדם שלנו פיתח עבורכם את CleanBrush, המוצר שיעשה עבורכן את העבודה בקלילות ויעילות!
הוא מנקה ביעילות רבה את החיידקים שעל המברשת שיניים שלכם, וכמובן במינימום מאמץ מצידכם.
CleanBrush משלב טכנולוגיה מתקדמת ועיצוב חכם כדי להעניק לכם שקט נפשי ומברשת שיניים נקייה בכל שימוש.
שאלנו לקוחות שהיו סקפטים בהתחלה
* סקר שביעות רצון, יולי 2024
98%
אמרו שהן מרוצים מה- CleanBrush שלנו!
94%
שיתפו שהם מרגישים בטוחים יותר להשתמש במברשת השיניים לאחר ניקוי ב-CleanBrush.
97%
דיווחו על שיפור משמעותית בניקיון מברשת השיניים שלהם.
95%
ציינו שהמוצר עזר להפחית את הצורך בהחלפת מברשות לעיתים תכופות, מה שהוביל לחיסכון כספי.
נתונים מעניינים שלקוחות שהיו סקפטים סיפרו לנו...
איך הCleanBrush בנוי?
הסבר על החלקים בCleanBrush שלנו 👇


החלק העליון
החלק העליון של הCleanBrush כולל בתוכו את הצג הדיגיטלי.
החלק התחתון
החלק התחתון של הCleanBrush כולל בתוכו את המכסה למברשות השיניים בעת השימוש.
החלק האמצעי
החלק האמצעי של הCleanBrush כולל בתוכו את המערכת הטכנולוגית האחראית לפעילות תקינה של המכשיר.
מיקום מברשות השיניים
הניחו את מברשות השיניים לפי הסרטון. ☝
איך מפעילים?
הזיזו את כף היד כמו שמוצג בסרטון ☝
איך מכבים?
הזיזו את כף היד כמו שמוצג בסרטון ☝
אלפי לקוחות מרוצים! 🤍
מה הלקוחות חושבים על ה- CleanPro שלנו?
מה ההבדל בין מברשת לפני ואחרי שימוש ב- CleanPro
עשינו לכם טיפה סדר.. 🤍

|
לפני שימוש | |
|---|---|---|
| מערכת ניקוי | ||
| מיליוני חיידקים | ||
| ניקוי יסודי | ||
| ניקוי הדורש מאמץ | ||
| שיפור היגיינת הפה | ||
| 14 ימי ניסיון |
שאלות ותשובות
למי מתאים המכשיר?
למי מתאים המכשיר?
אם אתם מחפשים פתרון מושלם לשמירה על מברשות שיניים מחיידקים, או שאתם רוצים להפוך את שגרת הצחצוח שלכם לבריאה ונקייה יותר.
CleanBrush הוא בדיוק מה שאתם צריכים! עם טכנולוגיה מתקדמת שמספקת ניקוי יסודי, המוצר שלנו מבטיח שמברשת השיניים שלכם תישאר נקייה, בריאה ורעננה.
המכשיר מתאים לכל סוגי המברשות?
המכשיר מתאים לכל סוגי המברשות?
כן, ה- CleanBrush מתאים לכל סוגי המברשות, כולל מברשות שיניים רגילות, חשמליות ועם ראשי מברשת שונים. המכשיר מותאם לשימוש עם כל מברשת שיניים, ומספק ניקוי יעיל ואיכותי לכל סוג.
איך המכשיר מנקה את המברשות מחיידקים?
איך המכשיר מנקה את המברשות מחיידקים?
ה- CleanBrush מנקה את מברשות השיניים מחיידקים בעזרת מערכת ניקוי עם טכנולוגיית חדשנית, אשר מנקה את החיידקים מהמברשת בצורה יעילה ומהירה. התהליך מבוצע בקלות, תוך שמירה על שלמות המברשת.
האם הניקוי עם המכשיר משפר את היגיינת הפה?
האם הניקוי עם המכשיר משפר את היגיינת הפה?
כן, הניקוי עם המכשיר משפר את היגיינת הפה בכך שהצחצוח הוא עם מברשת שיניים לאחר ניקוי חיידקים. וכך הוא מפחית את הסיכון לזיהומים בחלל הפה ושומר על מברשת שיניים נקייה, מה שמסייע לשמירה על בריאות הפה והחניכיים לאורך זמן.
אם לא אהבתי אפשר להחזיר?
אם לא אהבתי אפשר להחזיר?
אנחנו בטוחים במוצרים שלנו ולכן ניתן לפנות אלינו עד 14 ימים מקבלת הCleanPro ולהחזיר אותו אם לא אהבתם ולקבל החזר כספי!
ניסיתם ובכל זאת לא אהבתם? פנו אלינו בווצאפ או במייל ונשמח לעזור לכם ולעמוד לשירותכם! 🙏
מתי המשלוח יגיע אליי?
מתי המשלוח יגיע אליי?
משלוח עד לנקודת איסוף הקרובה לביתכם: ללא תוספת תשלום, תוך 7-21 ימי עסקים (בדרך כלל המשלוח מגיע תוך שבועיים)
משלוח עד הבית (מהיר יותר): בתוספת של 29.90₪, תוך 6-14 ימי עסקים (בדרך כלל המשלוח מגיע תוך שבוע וחצי)
*עקב המצב הביטחוני בישראל, הצפי יכול להתעכב. אין צורך לדאוג המשלוח בדרך אליכם.
איך עוקבים אחרי ההזמנה?
איך עוקבים אחרי ההזמנה?
כדי לעקוב אחר ההזמנה שלך: לחצו כאן
מה האמצעי תשלום שאתם מכבדים?
מה האמצעי תשלום שאתם מכבדים?
אמצעי התשלום שאנחנו מכבדים הם:
- כרטיס אשראי (מכבדים 7 סוגים)
- Apple Pay (אפל פיי)
{*בקרוב*} אפליקציית Bit (ביט)
*אפשר לשלם גם באמצעות אפליקציית PayBox (פייבוקס)
לתשלום באפשרות זו, לחץ כאן
התשלום באתר מאובטח?
התשלום באתר מאובטח?
כמובן! האתר עומד בפרוטוקול אבטחה והצפנת מידע הבינ”ל המחמיר SSL (Secure Sockets Layer) PCI 🔒